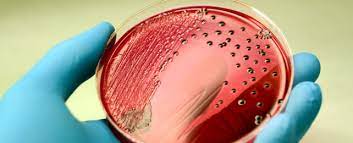

LONDON, Sept 5:If you’ve ever had a urinary tract infection (UTI) before, you know what a pain it can be. Not just because of the physical pains it causes, but because it can also be such a pain to go to the doctor, provide a urine sample, and wait for your results.
UTIs are extremely common, with nearly half of women getting one at some point in their lifetime. In order to test for a UTI, a urine sample needs to be sent to a hospital microbiology lab.
There, they will look for bacteria that cause infections and check if these bacteria are resistant to antibiotics. This is typically done by using a technique called agar plating. A small amount of urine is put on to a small round dish filled with a nutrient jelly called agar, which is kept warm overnight to allow any bacteria to grow.
This common technique has been around for nearly 140 years and remains the clinical standard in many hospitals. But in an age when we can instantly test for a COVID-19 infection, measure blood glucose with an electronic reader, and wear wrist watches that track our heart rates, why do we still use this old method that takes days to accurately diagnose a UTI?
It’s actually pretty clever
If an infection is suspected, it’s important to know what type of bacteria (if any) are present, how many are in your urine, and which antibiotic those bacteria can be treated with.
But urine samples can also contain a lot of other stuff – such as urea and salts, and different levels of acidity – that might affect the detection of bacteria. Spreading the urine on agar removes anything that might interfere with bacterial growth.
This technique also allows single cells in the sample to form blobs (called colonies) which are easy to count. The shape, colour, size and even smell of colonies can be used to indicate which types of bacteria are present. Some samples contain several different types of bacteria, and these must be isolated and tested separately.
It’s surprisingly hard to find alternative methods that can do all of these essential things without being affected by other urine components.
The best-known method
We have a lot of experience using the agar plating technique because we’ve used it for years. This means we have a pretty good understanding of how to make use of the results – not only in diagnosing a person’s infection but (where necessary) to adjust the treatment they are given.
But that doesn’t mean the system is perfect. The current method of agar plating takes several days to identify what antibiotics would treat the infection best – which is too long for a patient to wait. This means we have to start treating patients before the test results are known.
Sometimes this means patients have to switch drugs after a few days, which is inconvenient and expensive. Using more antibiotics fuels antibiotic resistance, making the problem worse in future. These problems are helping to drive innovation in microbiology testing.
New technologies still need improvement
Although current tests can measure bacteria and antibiotic resistance in urine, we need tests that can do this more rapidly to allow testing to happen before treatment. These methods ideally need to be portable and inexpensive so we can use them in the community, without sending samples to labs.
Recent progress suggests this may be possible. For example, digital cameras can detect if bacterial cells are growing on a microscopic scale or in diluted urine. While these methods take a few hours to check if an antibiotic will work, it’s still far quicker than agar plating.
Some hospital laboratories also now routinely use a technique called mass spectrometry, which measures fragments of a bacterial sample and compares them with a database to identify the bacteria. This speeds up the testing of colonies found on agar plates, replacing days of work previously needed to accurately identify bacterial species.
But while these new methods show promise, many are only at the research stage. And in the case of mass spectrometry, agar plating is still required for antibiotic susceptibility testing. Many of these technologies are also too big and expensive for a GP or pharmacy – so urine samples still need to be transported to hospital labs for analysis.
In the future, such technologies need to reduce the time it takes for a person to receive their diagnosis while remaining as affordable and accessible as agar plating. This is something our lab is working towards.
We’ve already found that we can manufacture smaller, more portable tests that are just as accurate as agar plating – and the results can be recorded with a cheap digital camera such as a smartphone. Our next stage of research is to check these “tiny tests” work with real patient samples.
It’s vital that some of the new, rapid UTI tests make their way into common practice, to ensure every case is treated quickly and effectively with the correct antibiotic. However, it will be some time before these and other new technologies are routinely used for diagnosis. For now, people who suspect they have a UTI still need to go to their GP in order to be diagnosed and given the proper medication. (The Conversation)
(AGENCIES)